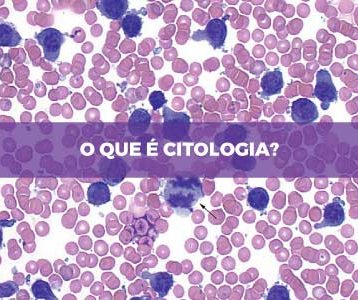

Veja este resumo completo sobre as organelas citoplasmáticas e suas funções! Leia até o fim para
Resultados para: citologia
A citologia é um ramo da biologia que aprofunda os estudos das células. A teoria celular...
Citologia é a área da Biologia responsável por estudar tudo que diz respeito sobre células, tanto...
A osmose é um tipo de transporte passivo muito importante para o funcionamento das células. Esse...
A Universidade Regional do Cariri, também conhecida como Urca, é uma das principais instituições de ensino...
A Universidade Federal do Rio Grande do Sul é uma das três melhores instituições públicas de...
Quer mandar bem no vestibular da Unemat? Veja os assuntos mais cobrados na prova, as obras
O vestibular da UERJ é dividido em duas fases. Na primeira, os candidatos respondem a questões...
O vestibular da Unesp possui duas fases, com provas bem diferentes na maneira de cobrar os...
A Universidade Federal do Rio Grande do Sul adotou o Sisu como meio de ingresso, mas...
O Exame Nacional do Ensino Médio (Enem) começou em 1998, como uma prova aplicada em todo...
Existe um jeito muito fácil de deixar seu estudo para o Enem mais efetivo, sabia? Conhecer...